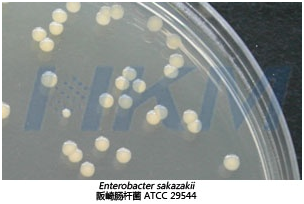
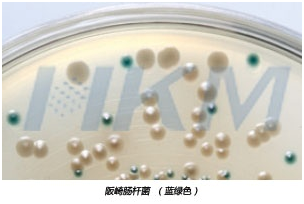

我公司針對目前乳制品行業(yè)及質(zhì)量監(jiān)測單位檢驗阪崎腸桿菌的需求及情況,對阪崎腸桿菌檢驗相應(yīng)的技術(shù)改進,使得阪崎腸桿菌檢出率較之前有很大的改進。擴充并完善了相關(guān)的微生物檢測試劑,使得技術(shù)操作人員能更準確、快捷的檢測出目標菌。
方案一:傳統(tǒng)微生物檢測法
依據(jù)GB 4789.40-2016食品衛(wèi)生微生物學檢驗克羅諾桿菌屬(阪崎腸桿菌)檢驗,推出成套的阪崎腸桿菌檢驗解決方案,為生產(chǎn)企業(yè)及檢驗單位提供方便。
第一法 克羅諾桿菌屬定性檢驗 操作步驟
1.1 前增菌和增菌 取檢樣100 g(mL)加入已預(yù)熱至44 ℃裝有900 mL 緩沖蛋白胨水的錐形瓶中,用手緩緩地搖動至充分溶解,36 ℃±1 ℃培養(yǎng)18 h±2 h。移取1 mL 轉(zhuǎn)種于10 mL mLST-Vm 肉湯,44 ℃±0.5 ℃培養(yǎng)24 h±2h。
1.2 分離 1.2.1 輕輕混勻mLST-Vm 肉湯培養(yǎng)物,各取增菌培養(yǎng)物1 環(huán),分別劃線接種于兩個阪崎腸桿菌顯色培養(yǎng)基平板,36 ℃±1 ℃培養(yǎng)24 h±2 h。 1.2.2 挑取至少5個可疑菌落,劃線接種于TSA 平板。25 ℃±1 ℃培養(yǎng)48 h±4 h。
1.3 鑒定 自TSA 平板上直接挑取黃色可疑菌落,進行生化鑒定??肆_諾桿菌屬的主要生化特征見表2??蛇x擇生化鑒定試劑盒或全自動微生物生化鑒定系統(tǒng)。
克羅諾桿菌屬的主要生化特征
生化試驗 | 特征 | |
黃色素產(chǎn)生 | + | |
氧化酶 | - | |
L-賴氨酸脫羧酶 | - | |
L-鳥氨酸脫羧酶 | (+) | |
L-精氨酸雙水解酶 | + | |
檸檬酸水解 | (+) | |
發(fā)酵 | D-山梨糖 | (-) |
L-鼠李糖 | + | |
D-蔗糖 | + | |
D-蜜二糖 | + | |
苦杏仁甙 | + | |
注:+>99%陽性: ->99%陰性;(+)90%-99%陽性;(-) | ||
1.4 結(jié)果與報告 綜合菌落形態(tài)和生化特征,報告每100 g(mL)樣品中檢出或未檢出克羅諾桿菌屬。
第二法 克羅諾桿菌屬的計數(shù) 操作步驟
2.1 樣品的稀釋 2.1.1 固體和半固體樣品:無菌稱取樣品100 g、10 g、1 g 各三份,加入已預(yù)熱至44 ℃分別盛有900 mL、90 mL、9 mL BPW 中,輕輕振搖使充分溶解,制成1:10 樣品勻液,置36 ℃±1 ℃培養(yǎng)18 h±2 h。分別移取1 mL 轉(zhuǎn)種于10 mL mLST-Vm 肉湯,44 ℃±0.5 ℃培養(yǎng)24 h±2 h。 2.1.2 液體樣品:以無菌吸管分別取樣品100 mL、10 mL、1 mL 各三份,加入已預(yù)熱至44 ℃分別盛有900 mL、90 mL、9 mL BPW 中,輕輕振搖使充分混勻,制成1:10 樣品勻液,置36 ℃±1 ℃培養(yǎng)18h±2h。分別移取1 mL 轉(zhuǎn)種于10 mL mLST-Vm 肉湯,44 ℃±0.5 ℃培養(yǎng)24 h±2 h。
2.2 分離、鑒定 同1.2,1.3。
2.3 結(jié)果與報告 綜合菌落形態(tài)、生化特征,根據(jù)證實為克羅諾桿菌屬的陽性管數(shù),查MPN 檢索表,報告每100 g(mL)樣品中克羅諾桿菌屬的MPN 值(見國標附錄B中表B.1)。
實驗操作所用培養(yǎng)基及生化試劑
功能階段 | 實驗 | 產(chǎn)品序號 | 產(chǎn)品名稱 | 規(guī)格 | 類別 |
前增菌 | 1 | 023130 | 緩沖蛋白胨水(BPW) | 250g | 瓶(干粉) |
CP0560A | 緩沖蛋白胨水(BPW) | 9 ml×20支 | 盒(管裝) | ||
增菌 | 2 | 022212 | 改良月桂基硫酸鹽胰蛋白胨肉湯基礎(chǔ)(MLST) | 250g | 瓶(干粉) |
SR0180 | 萬古霉素(改良月桂基硫酸鹽胰蛋白胨肉湯配套試劑) | 1 ml×10支 | 盒(西林瓶) | ||
CP0750 | 改良月桂基硫酸鹽胰蛋白胨肉湯(MLST-Vm) | 10 ml×20支 | 盒(管裝) | ||
平板分離 | 3 | CRM006 | 阪崎腸桿菌顯色培養(yǎng)基(DFI) | 1000 mL | 瓶(干粉) |
CRM006B | 阪崎腸桿菌顯色培養(yǎng)基(DFI) | 90mm×20 | 盒(平板) | ||
生化鑒定 | 4 | 024072 | 胰蛋白胨大豆瓊脂培養(yǎng)基(大豆消化酪素瓊脂培養(yǎng)基)TSA | 250g | 瓶(干粉) |
024079 | 胰蛋白胨大豆瓊脂培養(yǎng)基(大豆消化酪素瓊脂培養(yǎng)基)TSA | 90mm×20 | 盒(平板) | ||
5 | 029170 | 氧化酶試紙 | 10片/盒 | 盒 | |
6 | 075280 | L-賴氨酸脫羧酶培養(yǎng)基 | 20支 | 盒(西林瓶) | |
075290 | 氨基酸脫羧酶對照 | 20支 | 盒(西林瓶) | ||
7 | 075270 | L-鳥氨酸脫羧酶培養(yǎng)基 | 20支 | 盒(西林瓶) | |
8 | 075590 | L-精氨酸雙水解酶培養(yǎng)基 | 20支 | 盒(西林瓶) | |
075600 | 精氨酸雙水解酶對照 | 20支 | 盒(西林瓶) | ||
9 | 029110 | 無菌液體石蠟 | 10 mL×1支 | 瓶 | |
10 | 075090 | D-山梨醇 | 20支 | 盒(西林瓶) | |
11 | 075110 | L-鼠李糖 | 20支 | 盒(西林瓶) | |
12 | 075050 | D-蔗糖 | 20支 | 盒(西林瓶) | |
13 | 075560 | D-蜜二糖 | 20支 | 盒(西林瓶) | |
14 | 022120 | 西蒙氏檸檬酸鹽培養(yǎng)基 | 250 g | 瓶(干粉) | |
15 | 071870 | 阪崎腸桿菌生化鑒定盒 | 11種×10支 | 盒(西林瓶) |
不同培養(yǎng)基下菌種顯現(xiàn)出不同的菌落形態(tài)(菌株:阪崎腸桿菌 ATCC29544)

方案二:恒溫熒光快速檢測法
基于核酸水平的快速檢測技術(shù)目前日臻發(fā)展成熟,不少分子檢測技術(shù)已經(jīng)寫入標準當中,比如PCR、LAMP技術(shù);我司推出基于恒溫熒光檢測技術(shù)的微生物快速試劑盒,可用于食源性致病菌,包括阪崎腸桿菌。該試劑盒無需常規(guī)PCR中變性、退火、延伸等步驟不同溫度設(shè)計要求,只需提供一個適宜的恒定溫度即可。 因此,與常規(guī)PCR相比,恒溫熒光檢測技術(shù)更適合現(xiàn)場高通量快速檢測,具有簡單、快速、特異性強的特點。
操作流程圖
所需試劑、儀器及耗材列表
|
產(chǎn)品名稱 |
規(guī)格 |
備注 |
|
阪崎腸桿菌核酸檢測試劑盒(恒溫熒光法) |
24test/盒 |
詳見“產(chǎn)品信息1” |
|
緩沖胨水增菌液BPW |
250g/瓶 | |
|
移液槍、槍頭 |
1-10 μL、10-200 μL和100-1000 μL各一把 |
槍頭推薦國產(chǎn)槍頭即可。 |
|
離心機 |
最大轉(zhuǎn)速不低于12,000 rpm,離心機轉(zhuǎn)子支持200 μL和1.5 mL離心管離心。 |
詳見“產(chǎn)品信息2” |
|
恒溫金屬浴 |
—— |
詳見“產(chǎn)品信息3” |
產(chǎn)品信息1、阪崎腸桿菌核酸檢測試劑盒(恒溫熒光法)試劑盒組成
產(chǎn)品信息2、

產(chǎn)品信息3、

